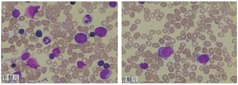

探讨ELANE相关先天性中性粒细胞减少症的临床特点、诊治及预后,加强对该病的认识。
对1例ELANE相关周期性中性粒细胞减少症患儿的临床资料进行整理,并进行文献复习。
患儿自出生起即反复因感染性疾病就诊,感染部位多为口腔、肺部及皮肤,动态监测外周血粒细胞大致呈周期性变化,骨髓象示粒细胞增生减低,存在ELANE基因一处杂合子突变:exon4:c.G570A。故诊断ELANE相关周期性中性粒细胞减少症。
临床医生对反复感染及多次粒细胞减少的病例应考虑先天性中性粒细胞减少症的可能,基因检测有助于确诊,规律的重组人粒细胞集落刺激因子治疗有助于减少感染并发症及改善生活质量。
版权归中华医学会所有。
未经授权,不得转载、摘编本刊文章,不得使用本刊的版式设计。
除非特别声明,本刊刊出的所有文章不代表中华医学会和本刊编委会的观点。
先天性中性粒细胞减少症(congenital neutropenia,CN)是由先天性基因缺陷引起的一组罕见的遗传异质性疾病,发病率约(2~3)例/百万[1]。其所涉及的基因主要有ELANE、SBDS、HAX1等。CN主要有两种临床表型:周期性中性粒细胞减少症(cyclic neutropenia,CyN)和重型先天性中性粒细胞减少症(severe congenital neutropenia,SCN),可表现为持续性或反复粒细胞减少以及由此导致的反复感染,并有转化为恶性血液病(骨髓增生异常综合征/急性白血病)的风险,还可累及中枢神经系统、心脏、胰腺、皮肤和肌肉等[2,3]。本文报道1例ELANE基因相关的CN患儿,并进行文献复习,以加强对该病的认识,从而提高罕见病诊断率及治疗率。
患儿,女,系G2P2,胎龄40周,于2017年10月22日顺产于福建省妇幼保健院,出生体重:4.11 kg,出生Apgar评分10分,其母亲孕期有妊娠期糖尿病,父母非近亲结婚,无家族遗传病史。患儿生后多次因感染性疾病就诊我院:患儿日龄22 d时(2017.11.13)以"反复发热4 d"为主诉入住我院新生儿科,病程中最高体温38.9 ℃,热时精神倦,四肢末梢凉,伴奶量减少,家属予"泰诺林"口服,体温退而复升。查体可见双侧腹股沟皮肤潮红,部分破溃,肛周皮肤潮红。第一次查血常规(见表1):WBC 11.08×109/L,NE 0.7×109/L;CRP 78.97 mg/L;PCT 0.25 ng/ml。完善胸片、腰穿等相关检查排除肺炎、颅内感染,考虑"新生儿败血症、粒细胞减少症、尿布性皮炎",予抗感染、重组人粒细胞集落刺激因子(recombinant human granulocyte stimulating factor,rhG-CSF)升粒细胞、静注人丙种球蛋白等治疗后好转,复查血常规大致正常范围。患儿1个月17 d时(2017.12.08)以"咳嗽4 d,加重1 d"为主诉入住我院儿科病房,咳嗽呈阵发性,咳时有痰,肺部查体可闻及湿啰音,我院查血常规(2017.12.08):WBC 5.79×109/L,NE 0.42×109/L;胸部X线:考虑支气管肺炎。入院后考虑"急性支气管肺炎、粒细胞减少症",予抗感染、雾化等治疗后症状缓解,复查血常规大致正常范围。患儿3个月18 d时(2018.02.09)因"间断发热9 d,血便3 d"再次就诊我院,病程中热峰39.0 ℃,家属予"右旋布洛芬栓"处理,体温反复;伴排黄色稀糊状便,4~5次/d,便中带血丝及少许黏液。查体见腹肌软,无压痛、反跳痛,未触及包块,肠鸣音5次/min。血常规(2018.02.09)示:WBC 5.11×109/L,NE 0.37×109/L,CRP 56.46 mg/L;粪常规:脓球(-),脂肪球(+++),黏液+,粪便OB:弱阳性,余大致正常。虽粪培养无阳性结果,仍考虑"肠道感染、粒细胞减少症",予抗感染、rhG-CSF升粒细胞、调节肠道菌群等治疗后好转,复查血常规大致正常范围。由于患儿反复感染,期间多次查血常规(表1)均提示中性粒细胞减少,波动于(0.04~0.63)×109/L,予抗感染及rhG-CSF治疗后均可缓解,予完善相关检查:T细胞亚群:CD3细胞:49.02%(41%~70%),CD4细胞27.38%(21%~47%),CD8细胞11.40%(16%~30%),NK细胞19.12%(9%~21%)。免疫球蛋白:IgG 10.60 g/L(7.51~15.60 g/L),IgM 0.56 g/L(0.46~3.04 g/L),IgA 0.45 g/L(0.82~4.53 g/L),补体C3 0.70 g/L(0.79~1.52 g/L),补体C4 0.13 g/L(0.16~0.38 g/L)。

患儿血常规和CRP结果
患儿血常规和CRP结果
| 日期 | 血常规 | CRP(mg/L) | |||
|---|---|---|---|---|---|
| WBC(×109/L) | NE(×109/L) | HB(g/L) | PLT(×109/L) | ||
| 2017.11.13 | 11.08 | 0.70 | 156 | 400 | 78.97 |
| 2017.11.23 | 13.88 | 3.39 | 152 | 378 | |
| 2017.12.08 | 5.79 | 0.42 | 141 | 248 | |
| 2017.12.14 | 9.57 | 1.14 | 131 | 556 | |
| 2018.02.09 | 5.11 | 0.37 | 103 | 488 | 56.46 |
| 2018.02.14 | 6.67 | 0.49 | 115 | 755 | |
注:WBC:白细胞,NE:中性粒细胞,HB:血红蛋白,PLT:血小板,CRP:C反应蛋白。
骨髓细胞形态学(见图1):(1)粒系增生减低,原始粒细胞0.5%,早幼粒细胞:0.5%,中性粒细胞中幼粒细胞1.0%,晚幼粒细胞2.0%,杆状核细胞1.0%,分叶核细胞1.0%;(2)红系增生,以中晚幼红细胞为主;(3)淋巴细胞比例明显增高,成熟淋巴细胞64%;(4)单核细胞比例增高,成熟单核细胞3.0%。基本除外药物、血液系统疾病及自身免疫等因素,予行血液和免疫系统疾病基因Panel检测(2018.01由北京海思特临床检验所完成),检出患儿存在ELANE基因一处杂合子突变:exon4:c.G570A,CSF3R及RUNX等基因无突变,患儿父母为正常野生型,考虑为患儿自身体细胞突变产生。

粒系增生减低,淋巴细胞及单核细胞比例升高。
因此结合患儿出生后即反复感染及外周血粒细胞大致呈周期性变化(见图2),并与感染发生时间大致平行,发病间歇期中性粒细胞数目可正常,基因检测提示ELANE基因存一处杂合子突变,骨髓细胞形态学可排除其他恶性血液病,细胞免疫及体液免疫检查大致正常。除此之外,患儿无小头畸形、特殊面容、肌力肌张力异常或心血管、泌尿系统发育异常等血液系统外表现,生长发育及智力等与同龄儿童无明显差别,诊断为:ELANE相关周期性中性粒细胞减少症。建议其动态监测血常规并规律使用rhG-CSF治疗,但其亲属依从性较差,此后仍多次并发感染(见表2),每次入院查血常规均提示中性粒细胞减少,以抗感染及rhG-CSF等治疗后病情均好转,发病间歇期外周血粒细胞可正常。



患儿出院后多次感染事件
患儿出院后多次感染事件
| 日期 | 患儿年龄 | 诊断 |
|---|---|---|
| 2018.07.14 | 8个月23d | 急性上呼吸道感染 |
| 2018.08.06 | 9个月15d | 疱疹性口腔炎、左阴唇蜂窝组织炎、肛周脓肿 |
| 2018.10.10 | 11个月19d | 疱疹性咽峡炎、急性腹泻 |
| 2019.02.06 | 1岁3个月 | 口腔溃疡 |
| 2019.04.28 | 1岁6个月 | 急性上呼吸道感染 |
| 2019.09.15 | 1岁10个月 | 口腔炎 |
| 2019.10.31 | 2岁 | 传染性单核细胞增多症、口腔炎 |
CN是因基因缺陷引起中性粒细胞成熟障碍所致的一组疾病,ELANE突变是最常见的病因。临床上主要表现为CyN或SCN,前者几乎均有ELANE基因突变,而后者约50%存在ELANE突变[2]。
ELANE基因位于染色体19 p13.3,包含五个外显子,编码267个氨基酸,其产物为中性粒细胞弹性蛋白酶。中性粒细胞弹性蛋白酶主要在幼稚细胞或早幼粒细胞阶段产生,贮存在粒细胞嗜天青颗粒中,参与病原微生物的降解等免疫过程,在固有免疫中发挥重要作用[3,4]。ELANE突变相关CN通常为杂合突变,呈常染色体显性遗传,其导致中性粒细胞减少的机制尚不明确,目前最为广泛接受的观点是其激活了未折叠蛋白反应及内质网应激反应而促进中性粒细胞的凋亡[3,5]。目前已报道超过200种ELANE基因突变[6,7],本例中ELANE的突变此前有文献报道过,可见于CyN或SCN,该突变产生一个新的剪接位点,使RNA剪接错误,造成氨基酸的缺失[8],这部分缺失的氨基酸构成一个表面环,存在于所有丝氨酸蛋白酶中,主要负责识别底物的特异性[9]。本例患儿父母ELANE基因为正常野生型,考虑患儿自身体细胞突变产生。
ELANE相关CN主要表现为反复发热及皮肤、口咽等部位的反复感染,患者常于婴幼儿时期反复因感染性疾病就诊,并发现外周血中性粒细胞减少[10,11]。CyN表现为周期性发热、口腔黏膜溃疡、肺部感染、外周血中性粒细胞减少(常<0.2×109/L,持续3~5 d),可伴血小板、单核细胞和网织红细胞计数的周期性变化,平均发作周期为21 d,间歇期可无任何临床表现[12]。超过60%的CyN患者每年可经历数次的口腔溃疡、牙龈炎、咽炎/扁桃体炎、皮肤感染等,肛周脓肿在粒细胞减少期常见,并发坏死性小肠结肠炎、腹膜炎及脓毒症者死亡风险极大。关于粒细胞呈现周期性变化的机制,目前认为中性粒细胞的数目受到CSF基因介导的增殖过程和成熟粒细胞反馈抑制的平衡:中性粒细胞可产生一种抑制因子来抑制祖细胞向中性粒细胞的分化,当这种抑制达到最大化时,中性粒细胞数目可降至最低,而当产生抑制因子的这群中性粒细胞耗尽时,这种抑制机制解除,即开始新一轮的循环。此后有研究发现中性粒细胞弹性蛋白酶是中性粒细胞膜蛋白中有此抑制作用的提取物的活性成分[9]。SCN患者感染情况常较周期性中性粒细胞减少症者更重,除了口咽部及皮肤感染,还可出现腹泻及肝脏、肺部的深部脓肿,出生后脐部感染可为首发表现。有别于CyN的是SCN患者外周血中性粒细胞计数无周期性波动,常<0.2×109/L,可伴不同程度单核细胞增多,且骨髓象可见粒细胞发育停滞于早幼粒细胞阶段[13]。
本例患儿虽因依从性影响而无严格监测外周血粒细胞变化,但患儿平均每月均因感染就诊1次,经抗感染和/(或)rhG-CSF治疗后均可好转出院,住院期间监测粒细胞数目变化可见其对rhG-CSF治疗敏感,而间歇期外周血粒细胞可至正常,结合其骨髓象未见明显粒细胞发育停滞现象,故考虑CyN可能性大。值得注意的是,CyN及SCN的临床表现也会有重叠而并不是完全决裂的,CyN的中性粒细胞数目变化有时并不那么规律,加之rhG-CSF治疗影响,有时很难区别CyN和SCN。同时,有些CyN虽然存在周期性变化,但由于粒细胞峰值较低而常被误认为SCN。因此在定义疾病表型时,除了考虑突变基因,还需考虑各种遗传和表观遗传因素以及环境因素的影响[3]。
临床上遇到以下情况应高度怀疑CN可能:反复发热、口腔溃疡、牙龈炎、皮肤感染及慢性严重的肝、肺脓肿等,超过3个月3次以上血常规提示中性粒细胞减少,常<0.5×109/L。ELANE相关CN的确诊需基因检测确认ELANE基因存在杂合型突变[6,14]。
rhG-CSF是治疗CN的首选方案。通常从小剂量[1~3 μg/(kg·d)]或中剂量[5 μg/(kg·d)]开始,可逐渐增加,治疗目标为维持外周血中性粒细胞数目>1.0×109/L。当中性粒细胞数目>1.0×109/L时,患者感染风险大大减小[6]。rhG-CSF用于治疗CyN是由Dale等[15]首次报道的,并通过随机对照试验(6例)证实rhG-CSF能大大减少CyN患者的感染几率,此后对这部分人以及重型慢性粒细胞减少国际登记处的另外350例患者随访24年发现,rhG-CSF能减少严重并发症的发生率,而无显著不良反应,其中最常见的不良反应为骨痛,在所有356例患者中有3例接受了造血干细胞移植并死亡,其中2例未接受rhG-CSF治疗,而另1例因过敏性紫癜在同时长期使用免疫抑制剂的患者则是因急性白血病进行了移植[16]。但此前有研究认为rhG-CSF剂量及使用时间与骨髓增生异常综合征/急性白血病的发生有关,当rhG-CSF剂量达到8 μg/(kg·d)时,恶性转化的风险增加,并认为恶性转化与获得性CSF3R基因突变有关[17,18,19,20]。
此外,由于需要长期规律的皮下注射rhG-CSF,年幼儿童常治疗依从性差,有研究表明长效rhG-CSF(培非格司亭)在减少用药频率的同时,可有效增加中性粒细胞数目,减少感染风险,改善患者的生活质量,而不明显增加治疗费用,因而不失为一个新的选择[21]。另外,Makaryan等[22]研究认为中性粒细胞弹性蛋白酶抑制剂可能对治疗CN有效,但仍需要更多临床研究支持。
造血干细胞移植是可治愈CN的唯一手段,对于rhG-CSF治疗无应答、需要高剂量rhG-CSF维持或有向骨髓增生异常综合征/急性白血病转化高风险的患者,可以考虑。但造血干细胞移植不仅风险大,且移植后骨髓增生异常综合征/急性白血病还有复发的可能[6,23]。
由于大部分CN患者未接受移植治疗,而需要长期rhG-CSF治疗以达到预防感染的目的,因此需要对这些患者进行长期管理。长期管理的内容包括监测外周血中性粒细胞数目(维持>1.0×109/L)、牙周护理、骨髓穿刺(每年1次检查骨髓细胞形态学及染色体、CSF3R/RUNX突变)、骨密度检查。在无感染等并发症期间,患者可正常上学及社交[6,24]。ELANE为常染色体显性遗传,每个携带ELANE致病变异的患者其子女均有50%的概率遗传该变异,本例患儿为自发突变,其父母无携带ELANE突变,但患者子女有遗传此变异的风险,因此对该患者,应建议其成年后妊娠期进行产前咨询及筛查。
CN由于罕见而可能在临床中被忽视,尤其是CyN在间歇期粒细胞数目正常,更容易漏诊。而一旦确诊,由于rhG-CSF治疗的有效性,患者常预后良好。因此临床上对于婴幼儿反复感染且多次查外周血粒细胞减少的患儿应警惕该病可能,以提高罕见病诊断率及治疗率。
所有作者均声明不存在利益冲突

























